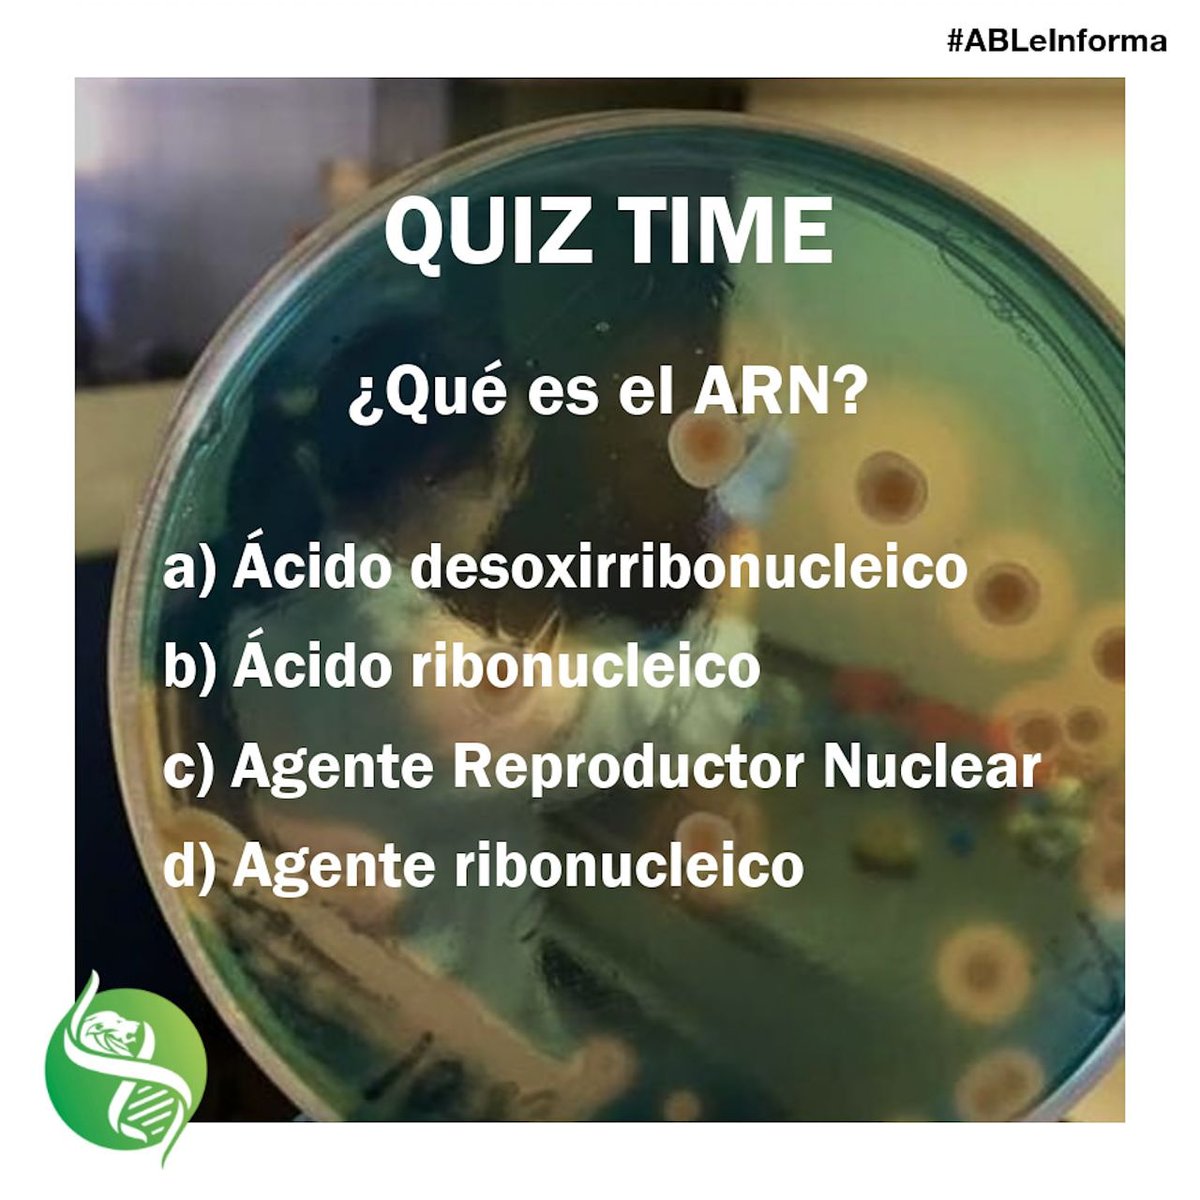
able_leon's tweet image. #BioQuiz

Y vosotros, ¿Sabéis lo que es el ARN?

#bioquiz search results
E agora entramos na moda do #BioQuiz. Entre esses insetos, apenas um é natural do Brasil. Todos os outros foram introduzidos aqui. Qual é o patriota?




Bora de #BioQuiz nível DIFÍCIL!! Nas imagens só têm um canídeo, qual? Credits: Michael Gäbler/ Geoff Gallice/ Pauk/ Chriest

Oi gente, vamos de mais um #BioQuiz hoje? . Pensando na diversidade anfisbênios quero que vocês respondam mais essa. Lembrem-se, a intenção aqui é conversarmos e aprendermos. . Embaixo tem a pergunta e alternativas. Hoje a noite trago o resultado.


Hoje é dia de #BioQuiz, será que vocês conseguem descobrir que dino rapinante é esse que está voando no céu?

e vamos sextar de #BioQuiz hoje ✨ a pergunta é: quais desses são crustáceos? a ordem das fotos é: 1 2 3 4 boa sorte 🧡





Checklist Bio Quiz#1 ข้อไหนถูก ข้อไหนผิด ระวังโดนหลอกน้าาา🤪 คอร์สตะลุยโจทย์ชีววิทยา A-Level สมัครเลย bit.ly/483vxJF ทดลองเรียนฟรี bit.ly/3JM20Ma #bioquiz #ชีวะเดอะเบรน #ชีวะพี่บิ๊ก #webythebrain #tcas69
Bio Quiz✨ เรื่องระบบสืบพันธุ์ คำตอบคืออะไร? ลองตอบตามกันได้เลยน้า คอร์สชีววิทยา A-Level รวมทุกบท สมัครเลย bit.ly/42fnHdM ทดลองเรียนฟรี bit.ly/4mEb5UK #bioquiz #ชีวะเดอะเบรน #ชีวะพี่บิ๊ก #webythebrain #tcas69
📢 QUIZ TIME HIV (Human Immuno deficiency virus) primarily targets which type of cells of immune system ❓ A) T cells B) B cells C) platelets D) Nerve cells #bioquiz #MedX

QUIZ TIME‼️‼️💡 BIOCHEMISTRY EDITION🧬🧬 Test your knowledge! 🤔 Can you answer this question? 📝 Share your response and tag a friend who needs to step up their biochemistry game! 👫 For more inquiries, register on our website @ medxlearn.com #BioQuiz #QuizTime

@GujBiotechUni congratulates its students for their outstanding performance at BIOCALYX 2024 organized by St. Xavier's College , Ahmedabad on 14/09/24. •1st Prize in Bio-Quiz •1st Prize in Debate •1st & 2nd Prize in Gene Tank #BIOCALYX2024 #StXaviersCollege #BioQuiz #Debate




#गुड़_गोबर Test Your Knowledge with Our #BioQuiz! Embrace the clean energy revolution with Bio Energy and see how much you know about the sustainable sources powering tomorrow's world. Provide your answers in the comments section. #SaveNatureForFuture #SaveEarthSaveLife

#गुड़_गोबर Test Your Knowledge with Our #BioQuiz! Embrace the clean energy revolution with Bio Energy and see how much you know about the sustainable sources powering tomorrow's world. Provide your answers in the comments section. #SaveNatureForFuture #SaveEarthSaveLife

The Department of Bioinformatics and Biosciences GENIX, Knowledge Dissemination Club organized a quiz competition "BioQuiz: Intricate world of Cellular Biology" on 4th June,2024. #BioQuiz #KnowledgeDisseminationClub #Genix




Test Your Knowledge with Our #BioQuiz ! Embrace the clean energy revolution with Bio Energy and see how much you know about the sustainable sources powering tomorrow's world. Provide your answers in the comments section. #CleanEnergy #GreenEnergy #MNREIndia

Test Your Knowledge with Our #BioQuiz ! Embrace the clean energy revolution with Bio Energy and see how much you know about the sustainable sources powering tomorrow's world. Provide your answers in the comments section. #CleanEnergy #GreenEnergy #MNREIndia

Test Your Knowledge with Our #BioQuiz ! Embrace the clean energy revolution with Bio Energy and see how much you know about the sustainable sources powering tomorrow's world. Provide your answers in the comments section. #CleanEnergy #GreenEnergy #MNREIndia

Test Your Knowledge with Our #BioQuiz ! Embrace the clean energy revolution with Bio Energy and see how much you know about the sustainable sources powering tomorrow's world. Provide your answers in the comments section. #CleanEnergy #GreenEnergy #MNREIndia

Test Your Knowledge with Our #BioQuiz ! Embrace the clean energy revolution with Bio Energy and see how much you know about the sustainable sources powering tomorrow's world. Provide your answers in the comments section. #CleanEnergy #GreenEnergy #MNREIndia

Department of Biotechnology and Biogeneron Association conducted BIOQUIZ’24 intercollegiate event sponsored by DBT Star college Scheme – Status on 28th February 2024. #bioquiz #intercollegiate #DrNGP #NGPArtsAndScience

Bora de #BioQuiz nível DIFÍCIL!! Nas imagens só têm um canídeo, qual? Credits: Michael Gäbler/ Geoff Gallice/ Pauk/ Chriest

E agora entramos na moda do #BioQuiz. Entre esses insetos, apenas um é natural do Brasil. Todos os outros foram introduzidos aqui. Qual é o patriota?




📢 QUIZ TIME HIV (Human Immuno deficiency virus) primarily targets which type of cells of immune system ❓ A) T cells B) B cells C) platelets D) Nerve cells #bioquiz #MedX

Vibrant gathering of avid minds at Gujarat Biotechnology University in the BioQuiz competition. Congratulations to the winners. Thank you for the active participation of faculties and students from all over Gujarat. #biotechnology #BioQuiz





Something went wrong.
Something went wrong.
United States Trends
- 1. #HardRockBet 3,951 posts
- 2. Arsenal 277K posts
- 3. Tottenham 87.1K posts
- 4. #ARSTOT 15K posts
- 5. #AskFFT 1,182 posts
- 6. Thomas Frank 6,247 posts
- 7. Mason Rudolph 3,005 posts
- 8. Richarlison 9,109 posts
- 9. #COYG 6,781 posts
- 10. Klay 43.3K posts
- 11. Merino 20.3K posts
- 12. Raya 17.2K posts
- 13. Trossard 16.1K posts
- 14. Great for 60 N/A
- 15. Sean Tucker 1,137 posts
- 16. #sundayvibes 7,908 posts
- 17. PEAKTOOZ 2,241 posts
- 18. Emanuel Wilson N/A
- 19. Full PPR 1,587 posts
- 20. NFL Sunday 7,980 posts